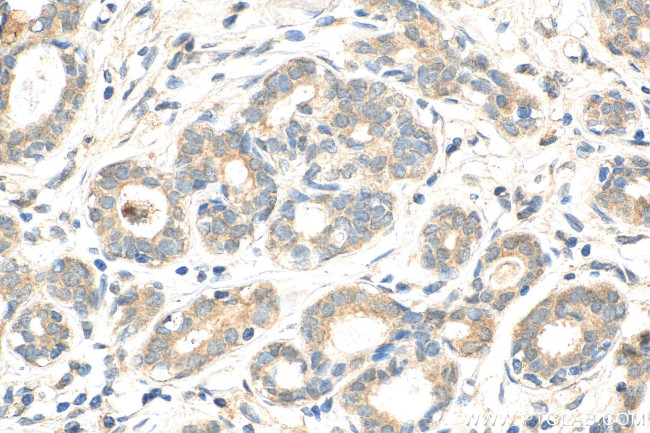
ATF2 Antibody in Immunohistochemistry (Paraffin) (IHC (P))

Search
Proteintech
ATF2 Polyclonal Antibody
{{$productOrderCtrl.translations['antibody.pdp.commerceCard.promotion.promotions']}}
{{$productOrderCtrl.translations['antibody.pdp.commerceCard.promotion.viewpromo']}}
{{$productOrderCtrl.translations['antibody.pdp.commerceCard.promotion.promocode']}}: {{promo.promoCode}} {{promo.promoTitle}} {{promo.promoDescription}}. {{$productOrderCtrl.translations['antibody.pdp.commerceCard.promotion.learnmore']}}
产品信息
14834-1-AP
种属反应
已发表种属
宿主/亚型
分类
类型
抗原
偶联物
形式
浓度
规格
纯化类型
保存液
内含物
保存条件
运输条件
产品详细信息
This antibody is a rabbit polyclonal antibody raised against a peptide mapping within human ATF2. The calculated molecular weight of ATF2 is 55 kDa, but the modified ATF2 protein is about 70 kDa.
靶标信息
The transcription factor ATF-2 (also called CRE-BP1) binds to both AP-1 and CRE DNA response elements and is a member of the ATF/CREB family of leucine zipper proteins. ATF-2 interacts with a variety of viral oncoproteins and cellular tumor suppressors and is a target of the SAPK/JNK and p38 MAP kinase signaling pathways. Various forms of cellular stress, including genotoxic agents, inflammatory cytokines and UV irradiation, stimulate the transcriptional activity of ATF-2. Cellular stress activates ATF-2 by phosphorylation of Thr69 and Thr71. Both SAPK and p38 MAPK have been shown to phosphorylate ATF-2 at these sites in vitro and in cells transfected with ATF-2.
仅用于科研。不用于诊断过程。未经明确授权不得转售。
生物信息学
蛋白别名: Activating 2; Activating transcription factor 2; ATF2; bZIP transcription factor; cAMP response element-binding protein CRE-BP1; cAMP responsive element binding protein 2, formerly; cAMP-dependent transcription factor ATF-2; CREB-2; cyclic AMP response element-binding protein (HB16); Cyclic AMP-dependent transcription factor ATF-2; Cyclic AMP-responsive element-binding protein 2; HB16; histone acetyltransferase ATF2; MGC111558; MXBP protein; OTTHUMP00000205345; OTTHUMP00000205347; OTTHUMP00000205348; OTTHUMP00000205350; OTTHUMP00000205352; OTTHUMP00000205353; OTTHUMP00000205354; unnamed protein product
基因别名: Atf-2; ATF2; CRE-BP; CRE-BP1; CREB-2; CREB2; CREBP1; D130078H02Rik; D18875; HB16; mXBP; Tg(Gzma-Klra1)7Wum; TREB7
UniProt ID: (Human) P15336, (Mouse) P16951
Entrez Gene ID: (Human) 1386, (Mouse) 11909